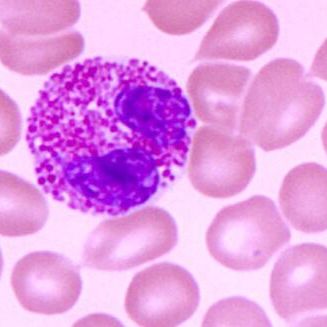
产品封面图

相关产品推荐更多 >
万千商家帮你免费找货
0 人在求购买到急需产品
- 详细信息
- 文献和实验
- 技术资料
- 品系:
详见说明书
- 细胞类型:
科研细胞
- 肿瘤类型:
详询
- 供应商:
上海晅科生物科技有限公司
- 库存:
100
- 英文名:
KM933
- 生长状态:
贴壁
- 年限:
详见说明书
- 运输方式:
复苏
- 器官来源:
详询
- 是否是肿瘤细胞:
详见说明书
- 细胞形态:
上皮样
- 免疫类型:
详询
- 物种来源:
B淋巴;EBV转化
- 相关疾病:
详见说明书
- 组织来源:
详询
适用范围:
本产品仅限于科学研究,绝不可作为人类或者动物疾病的治疗产品使用。
细胞特性:
1) 规格:T25瓶或者1mL冻存管包装
2) 含量:>1x10^6
3) 污染:支原体、细菌、酵母和真菌检测为阴性
4) 来源:见说明
5) 形态:请直接向我司客服索取
1)运输和保存
可选择干冰运输及发送复苏存活细胞方式:
1.干冰运输,收到后立即转入液氮或者-80度冰箱冻存或直接复苏;
2.存活细胞,收到后应继续生长,传代达到细胞生长状态良好时,再进行冻存。具体操作见细胞培养步骤。
3.收到细胞后请拍照,3天内如果发现污染,请及时拍照与我们联系。
2) 细胞传代:如果细胞密度达80%-90%,即可进行传代培养。
对于贴壁细胞,传代可参考以下方法:
1.弃去培养上清,用不含钙、镁离子的PBS润洗细胞1-2次。
2.加2ml消化液(0.25%Trypsin-0.53mM EDTA)于培养瓶中,置于37℃培养箱中消化1-2分钟,然后在显微镜下观察细胞消化情况,若细胞大部分变圆并脱落,迅速拿回操作台,轻敲几下培养瓶后加少量培养基终止消化。
3.按6-8ml/瓶补加培养基,轻轻打匀后吸出,在1000RPM条件下离心4分钟,弃去上清液,补加1-2mL培养液后吹匀。
4.将细胞悬液按1:2到1:5的比例分到新的含8ml培养基的新皿中或者瓶中。
细胞接受后的处理:
1) 收到细胞后,请检查是否漏液,如果漏液,请拍照片发给我们。
2) 请先在显微镜下确认细胞生长状态,去掉封口膜并将T25瓶置于37℃培养约2-3h。
3) 弃去T25瓶中的培养基,添加6ml新的的完全培养基。
4) 如果细胞长满(90%以上)请及时进行细胞传代。
5) 接到细胞次日,请检查细胞是否污染,若发现污染或疑似污染,请及时与我们取得联系。
1,细胞冻存时,弃去培养基后,PBS清洗一遍后加入1ml胰酶,细胞变圆脱落后,加入1ml含血清的培养基终止消化,可使用血球计数板计数。
2,4min 1000rpm 离心去掉上清。加1ml血清重悬细胞,根据细胞数量加入血清和DMSO,轻轻混匀,DMSO终浓度为10%,细胞密度不低于1x10E6/ml,每支冻存管冻存1ml细胞悬液,注意冻存管做好标识。
3,将冻存管置于程序降温盒中,放入-80度冰箱,至少2个小时以后转入液氮灌储存。记录冻存管位置以便下次拿取。
ATCC是全球首屈的生物材料资源和标准组织,其使命主要集中在标准参考微生物,细胞系和其他材料的获取,鉴定,生产,保存,开发和分销。在保持传统收集材料的同时,ATCC开发出高质量的产品,标准和服务,以支持改善全球人口健康的科学研究和突破。
晅科生物致力于为国内科研用户提供Z优质的产品,最完善的服务。帮助您实验顺利。
如需订购KM933 EB病毒转化的人B淋巴细胞,请联系我们,此外公司还提供:
| 人黑色素瘤细胞 |
| 人胶质母细胞瘤细胞 |
| 人甲状腺癌细胞 |
| 人膀胱癌细胞 |
| 人横纹肌瘤细胞 |
| 大鼠膝关节软骨细胞 |
| 大鼠皮肤成纤维样细胞 |
| 人乳腺癌细胞 |
| 人肺腺癌细胞 |
| 大鼠主动脉血管内皮细胞 |
| 人脑瘤细胞 |
| 大鼠滑膜细胞 |
| 猫肾细胞 |
| 人急性早幼粒白血病细胞 |
| 人类急性髓系白血病细胞 |
| 人低分化胃癌细胞 |
风险提示:丁香通仅作为第三方平台,为商家信息发布提供平台空间。用户咨询产品时请注意保护个人信息及财产安全,合理判断,谨慎选购商品,商家和用户对交易行为负责。对于医疗器械类产品,请先查证核实企业经营资质和医疗器械产品注册证情况。
文献和实验on the gamma1, gamma2, gamma3, and alpha2 heavy chains (they are designated as G1m, G2m, G3m, and A2m allotypes, respectively), and on the kappa light chain (Km allotypes). Gm-Am allotypes are inherited in fixed combinations, or Gm-Am haplotypes, owing
酸性磷酸酯酶动力学性质分析 米氏常数(Km)和最大反应速度(Vm)的测定 [原理] 在温度、pH及酶浓度恒定的条件下,底物浓度对酶促反应的速度有很大的影响。在底物浓度很低时,酶促反应的速度(v)随底物浓度的增加而迅速增加;随着底物浓度的继续增加,反应速度的增加开始减慢;当底物浓度增加到某种程度时,反应速度达到一个极限值(Vmax
原理: 当环境的温度、pH和酶浓度等条件一定时,酶促反应的初速度(V)随底物浓度[S]增高而加快,直到达到一个极限,即最大反应速度(V)。底物浓度与酶反应初速度的这种关系,米一曼(Michaelis—Menten)氏推导出如下公式,称为米—曼氏方程式: 式中Km称为米式常数。Km是反应速度等于最大反应速度一半(v=V/2)时底物的浓度。Km是酶的特征性常数。测定Km是研究酶动力学的一种